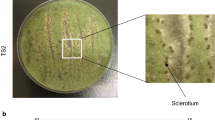

Abstract
The genus of Monascus was nominated by van Tieghem in 1884, but its fermented product—red mold rice (RMR), namely red yeast rice, has been used as folk medicines, food colorants, and fermentation starters for more than thousands of years in oriental countries. Nowadays, RMR is widely developed as food supplements around the world due to its functional compounds such as monacolin K (MK, also called lovastatin) and γ-aminobutyric acid. But the usage of RMR also incurs controversy resulting from contamination of citrinin (a kind of mycotoxin) produced by some Monascus strains. In the past decade, it has made great progress to Monascus spp. at the genetic level with the application of molecular biology techniques to restrain the citrinin production and increase the yields of MK and pigment in RMR, as well as aid Monascus classification and phylogenesis. Up to now, hundreds of papers about Monascus molecular biology (MMB) have been published in the international primary journals. However, to our knowledge, there is no MMB review issued until now. In this review, current understanding of Monascus spp. from the view of molecular biology will be covered and insights into research areas that need to be further investigated will also be discussed.
Similar content being viewed by others
Avoid common mistakes on your manuscript.
Introduction
The genus of Monascus, belonging to the family Monascaceae, the order Eurotiales, the subclass Eurotiomycetidae, and the class Eurotiomycetes (Geiser et al. 2006), was nominated by van Tieghem in 1884. In many oriental countries, Monascus strains are inoculated to steamed rice to produce red mold rice (RMR), which is also called Hongqu, red yeast rice, Hon-Chi, Anka, red koji, red Chinese rice, and red fermented rice—a kind of traditional fermentation food and a traditional Chinese medicine for curing indigestion, dysentery, and relieving pain (Li and Guo 2003; Lin et al. 2008). It has been proved that RMR contains many kinds of beneficial compounds, such as edible pigments (widely used as the natural food colorant), monacolins (a group of anti-hypercholesterolemic agent), gamma-amino butyric acid (GABA, a kind of hypotensive agent), dimerumic acid (a natural antioxidant), sterols, isoflavones, unsaturated fatty acids, protease, and esterase (Lin et al. 2008; Shi and Pan 2011; Patakova 2013). In recent years, many scientific researches demonstrated that RMR had potential therapeutic action to several chronic diseases, even to prevention of cancer development (Liu et al. 2003; Arunachalam and Narmadhapriya 2011; Lee and Pan 2011; Hsu and Pan 2012; Lee and Pan 2012, 2013; Shi and Pan 2012; Hsu et al. 2013), so RMR has been utilized as a popular dietary supplement worldwide. However, the discovery of citrinin (a kind of mycotoxin) production by Monascus strains aroused controversy over the safety of RMR (Blanc et al. 1995a; Wang et al. 2005). Now, different countries show different attitudes to RMR and related products. For instances, effort to use Monascus pigments as food colorants in Europe and the USA was ceased, while RMR is permitted successive usage as food additives in Asian countries such as China with the maximum residue level (Zhou et al. 2012; Patakova 2013).
In recent years, several genes involved in the biosynthesis of citrinin, monacolin K (MK), and pigments and G protein signaling pathway (Shimizu et al. 2005, 2007; Chen et al. 2008a, 2010; Yang et al. 2012; Balakrishnan et al. 2013; Li et al. 2010a, 2014) have been cloned and analyzed, which made an important step forward in understanding the secondary metabolism in Monascus spp.. Although hundreds of papers about Monascus molecular biology (MMB) have been published in primary research journals, there is still no MMB review issued up to now. To help audience understand the recent research in rapidly progressing and emerging areas of MMB, available knowledge on Monascus spp., including molecular classification and phylogenesis, gene clusters of secondary metabolites, related genes to G protein signal transduction pathway, and genomic information, will be covered in this review, and insights into research areas that need further to be investigated will also be discussed, enhancing our understanding of Monascus spp. in the view of fungal biology.
Molecular classification and phylogenesis of Monascus spp.
Monascus spp., a kind of filamentous fungi, isolated from RMR, was classified and named by van Tieghem in 1884. Since the genus of Monascus was recognized into three species including Monascus ruber, Monascus pilosus, and Monascus purpureus in 1983 (Hawksworth and Pitt), more than 20 species, which are listed in Table 1, have been recorded in documentary materials (Li and Guo 2003; Park and Jong 2003). In fact, only nine Monascus species have been widely accepted. The existing disparity may be attributed to the synonyms of Monascus spp.. Therefore, some molecular markers such as random amplified polymorphic DNA (RAPD), D1/D2 regions of large subunit ribosomal RNA (LSU rRNA), internal transcribed spacer (ITS) and partial β-tubulin genes, Monascus retrotransposon (MRT) as well as inter-simple sequence repeat (ISSR) and sequence-related amplified polymorphism (SRAP) have been used to assist the Monascus classification and phylogenesis, which are free from the effects of variation of cultural conditions on morphological and physiological characteristics, providing alternative tools for discrimination of Monascus spp. (Park et al. 2004).
RAPD marker was firstly used to study the genetic relationship within 25 isolates of Monascus, and cluster analysis indicated these isolates represented four genetic lineages of Monascus, suggesting that a relatively restricted genetic source of Monascus isolates is used in food products in Asian countries (Lakrod et al. 2000). Shinzato et al. (2009) also demonstrated that RAPD was available to differentiate closely related Monascus strains. Based on the sequence information of D1/D2 regions of LSU rRNA genes, 65 strains of Monascus and Xeromyces were clustered into five groups with Aspergillus anthodesmis, Penicillium inflatum, Cephalotheca sulfurea, Albertiniella polyporicola, and Aporothielavia leptoderma as outgroup control (Park and Jong 2003). Later, 17 ATCC strains of Monascus species were differentiated according to the sequence comparison of ITS and partial β-tubulin genes (Park et al. 2004). These investigations showed that the combination of morphological analysis and sequence comparison can not only differentiate Monascus species, but also confirm the synonyms of some species. It is noteworthy that the phylogenetic analysis based on β-tubulin gene is consistent with alignments postulated by DNA sequences of the D1/D2 region of LSU gene, but phylogenetic analysis with ITS sequence information should be cautiously used due to the insertion and deletion of DNA sequence (Park et al. 2004). Chen et al. (2007) inferred that the species of Monascus can be grouped by the presence or absence of MRT elements via Southern hybridization based on phylogenetic subgroups established with the partial β-tubulin gene, but this method is a time-consuming process. In addition, some DNA markers are developed to study genetic diversity, classification, and identification of species according to the structural feature of genomic DNA, such as inter-simple sequence repeat (ISSR) marker and sequence-related amplified polymorphism (SRAP) technique. In 2011, the genetic diversities of 37 Monascus isolates from different samples gathered in China, and 14 reference strains from the microbial collections in the world, were analyzed by ISSR and SRAP. According to the dendrogram produced by two sets of data, 51 tested strains were grouped into four clusters at the 70 % similarity level, sharing great similarity with each other except minor differences in the subgroups. And the analysis was in agreement with morphological observations, revealing that both SRAP and ISSR have potential to discriminate the Monascus strains (Shao et al. 2011).
In short, it goes to show that these DNA molecular markers will be alternative approaches to investigate the polymorphism of Monascus spp. in both interspecies and intraspecies. But different molecular markers have their own applicable scopes based on different experiment principles and target DNA region.
Functional investigation on interest of genes (gene clusters) of Monascus spp.
In the contemporary era, a number of investigations have proven that besides Monascus pigments, Monascus spp. can produce many other bioactive compounds including monacolins, GABA, dimerumic acid, and so on, and also citrinin, a kind of mycotoxin (Aniya et al. 1999; Blanc et al. 1995a; Su et al. 2003; Patakova 2013). So, as to efficiently increase the amount of functional materials but decrease the citrinin contents, it becomes a research hotspot to illuminate the biosynthetic pathways of the metabolites in Monascus spp.. With the introduction of molecular genetic tool into Monascus research, the genes involved in the biosynthesis of several main metabolites from Monascus spp. have been or are being investigated. In the following sections, the available transformation methods, gene (cluster) involving in the synthesis of citrinin, MK and pigment in Monascus spp. will be described in detail.
DNA transformation processes of Monascus spp.
In the past decade, molecular mechanisms involving in metabolism and development of filamentous fungi have made great progress since the first genetic manipulation of Neurospora crassa was reported by Case et al. (1979). However, there was little genetic knowledge of Monascus due to lack of suitable molecular genetic tools until the late of the twentieth century. Therefore, it is necessary to develop efficient transformation methods to introduce exogenous DNA sequence into the genomic DNA of Monascus. Since the first genetic transformation of Monascus spp. was reported via genomic DNA-mediated transformation (GDMT) in 2003 (Lakrod et al. 2003a), biolistic bombardment (Lakrod et al. 2003b), polyethylene glycol-mediated protoplast transformation (PEG-MPT), Agrobacterium tumefaciens-mediated transformation (ATMT) (Campoy et al. 2003), and restricted-enzyme mediated integration (REMI) technique also have been successfully applied to Monascus genetic transformation (Zhou et al. 2006; Chen et al. 2008b). Compared with the transformation methods described above, it can be found that the transformants obtained by GDMT were always mitotically unstable (Lakrod et al. 2003a), and transformation efficiency was lower with biolistic bombardment or PEG-MPT (Lakrod et al. 2003b; Zhang et al. 2013), while REMI technique was a time-consuming process dependent on the selection of restricted-enzyme (Zhou et al. 2006; Chen et al. 2008a). Instead of the aforementioned shortages, ATMT, with its appealing features, such as no protoplast preparation, higher transformation efficiency, a simpler manipulation process, and more stable DNA integration, may be the most suitable molecular transformation method to Monascus spp. until now (Michielse et al. 2005). The transformation methods applied to Monascus spp. in recent years are listed in Table 2.
Gene clusters of secondary metabolites in Monascus spp.
Filamentous fungi can produce diverse secondary metabolites mainly including polyketides (PKs), non-ribosomal peptides (NRPs), terpenes (TPs), and indole terpenes (ITPs) (Staunton and Weissman 2001; Fox and Howlett 2008; Brakhagea and Schroeckha 2011; Wiemann et al. 2013). The biosynthetic genes responsible for these compounds are usually clustered together, which have been proved by many researches (Fox and Howlett 2008; Brakhagea and Schroeckha 2011; Brakhage 2013). In Monascus spp., citrinin, pigment, and MK are typical PKs compounds, which were catalyzed by polyketide synthases (PKSs) consisting of a minimal set of ketosynthase (KS), acyltransferase (AT), and acyl carrier protein (ACP) domains (Staunton and Weissman 2001; Lackner et al. 2012). According to this structural feature, several PKSs in Monascus spp. were cloned and analyzed functionally, which will be described in the following sections.
Citrinin gene cluster
Citrinin was firstly discovered as an antibacterial factor named monascidin A in RMR (Wong and Koehler 1981). Later, Blanc et al. (1995a, b) confirmed that monascidin A was the same compound as citrinin, a kind of mycotoxin, which had been identified as a secondary metabolite in a variety of fungi such as Aspergillus spp. and Penicillium spp.(Sweeney and Dobson 1998; Malmstrøm et al. 2000). For preventing the contamination of Monascus-fermented products from citrinin, many scientists have been focusing on the breeding and optimization of fermentation conditions to reduce citrinin in RMR (Chen and Hu 2005; Lee et al. 2007; Pattanagul et al. 2008; Hajjaj et al. 2012), but it is very difficult to be absolutely eliminated. Hence, many current researches focus on the isolation of the gene cluster involved in citrinin biosynthesis and elucidation of the bio-catalyzed process in Monascus spp..
In 2005, pksCT, a PKS gene (GenBank accession no. AB167465) in M. purpureus was first isolated with degenerate primers targeting the conserved KS domain of a fungal PKS, which had a length of 7,838 bp with a single 56-bp intron, and encoded a 2,593-amino acid protein that contained putative domains for KS, AT, ACP, and a methyltransferase (Shimizu et al. 2005). Following these information, a pksCT-inactivated mutant without the KS domain or the ACP domain was constructed, which did not produce citrinin, also had no influence on pigment production, demonstrating that pksCT was directly responsible for the citrinin biosynthesis in M. purpureus. However, the resulting pksCT disruptant was unstable and could become its revertant by repeat cultivation (Shimizu et al. 2005). Based on the cloned DNA sequences, a 21-kbp fragment (GenBank accession no. AB243687) was cloned including four open reading frames (ORFs) (orf1, orf2, orf3, and orf4) in the 5′-flanking region and one ORF (orf5) in the 3′-flanking region in the vicinity of pksCT from M. purpureus, and a major activator (ctnA) of citrinin biosynthesis was also identified by site-specific recombination (Shimizu et al. 2007). Sequence analysis revealed that ctnA gene encoded a protein sharing significant similarity to the members of the Zn(II)2Cys6 binuclear DNA binding proteins. The disruption of ctnA caused large decreases in the transcription of pksCT and orf5 (the putative membrane transporter), as well as significant reduction of citrinin production, while complementation of the ctnA disruptant restored the transcription of citrinin-related gene and its production. Fu et al. (2007) also constructed a pksCT-deleted mutant of Monascus aurantiacus, resulting to a 97.2 % decrease of citrinin amount, while the production of red and yellow pigments increased to 49.4 and 28.8 %, respectively. Later, Li et al. (2012) isolated a larger DNA fragment with 43-kb length from M. aurantiacus by probes hybridization with a fosmid library, which was deduced as 16 ORFs including the homologous gene of pksCT, 7 ORFs (ctnD, ctnE, orf6, orf1, ctnA, orf3, and orf4) in the 5′-flanking region and 8 ORFs in the 3′-flanking of pksCT (orf5, ctnF, orf7, ctnR, orf8, ctnG, ctnH, and ctnI). Then, they deleted the orf4 (ctnB, encoding for a predicted oxidoreductase) through homologous recombination and the results revealed that ΔctnB mutants barely produced citrinin, suggesting that the ctnB gene is directly involved in citrinin biosynthesis. Based on the plausible citrinin biosynthetic gene cluster cloned by Shimizu et al. (2005), Sakai et al. (2008) introduced an additional copy of activator gene (ctnA) together with the gene cluster into Aspergillus oryzae, and developed a heterologous expression system to produce citrinin. In order to decrease the contamination of citrinin, several genes in citrinin biosynthetic cluster in Monascus spp. were disrupted to create citrinin-free or citrinin-depressed mutants, providing a potential approach to genetically modify the Monascus strains (Jia et al. 2010; Li et al. 2013).
MK gene cluster
In the 1970s, Japanese scholar Ando discovered MK in the fermentation broth of M. ruber, the same substance as lovastatin and compactin produced by Aspergillus terreus and Penicillium citrinum, respectively (their chemical structures were listed in Table 3), which can significantly reduce serum cholesterol level by competitively inhibiting the activity of 3-hydroxy-3-methyl glutaryl coenzyme A (HMG-CoA) reductase (Endo 1979). Afterwards, Ando further isolated several MK analogs from Monascus spp. including monacolin L, X, J, M, dihydroerinolin and dihydromonalin L, and all of them possessed the same basic structure as MK and strong cholesterol-lowering effect (Endo et al. 1985, 1986). Nowadays, MK has become one of the most secure drugs for the reduction of cholesterol with best application effect, attracting extensive attentions from China and abroad (Grabley and Thiericke 1999).
As what was mentioned before, some strains from both Aspergillus spp. and Penicillium spp. can produce MK (lovastatin) and compactin, and it has been proved that two PKSs (LNKS and LDKS, encoded by lovB and lovF), transesterase (lovD), enoyl reductase (ER) (lovC), and P450 monooxygenase (lovA) are involved in the biosynthesis of lovastatin (Kennedy et al. 1992; Hutchinson et al. 2000; Sorensen et al. 2003a, b). Based on the conserved DNA sequences of the KS domain of the lovB gene in Aspergillus terreus, MK biosynthetic gene cluster spanning 42 kb (GenBank accession no. DQ176595) was also cloned from a bacterial artificial chromosome library in M. pilosus BCRC38072 (Chen et al. 2008b). And bioinformatics analysis revealed that nine genes of MK biosynthetic gene cluster shared strong homology with the lovastatin-related and compactin-related genes in Aspergillus terreus and P. citrinum, respectively (Chen et al. 2008b), which were presumed to be required for MK biosynthesis. Disruption of mokA (predicted to be responsible for the synthesis of the nonaketide skeleton) caused the complete loss of MK production in M. pilosus BCRC38072, demonstrating the involvement of mokA in MK biosynthesis (Chen et al. 2008b). While deleted mutants of mokB (presumed to be responsible for the synthesis of the diketide skeleton) lost the ability to produce MK but accumulated intermediate monacolin J, indicating mokB is responsible for the diketide side chain synthesis of MK (Sakai et al. 2009). To confirm the function of mokH gene (predicted as an activator for MK synthesis), it was cloned and expressed in M. pilosus driven by the promoter of glyceraldehydes-3-phosphate dehydrogenase, and the transcript of mokH and MK production in the transformants were significantly higher than those of the wild-type strain. In addition, gene expression in MK biosynthetic gene cluster in the transformant appeared earlier than that in the control. These results indicated that mokH upregulated the transcription of MK biosynthetic genes and increased its production (Chen et al. 2010).
Pigment gene cluster
Monascus pigments (MPs), natural food colorants, usually include yellow, orange, and red, total three kinds of constituents, which have been widely used in food industries in the world, especially in Southeastern Asian countries (Feng et al. 2012; Patakova 2013). In recent years, MPs have been proved with multiple biological functions, such as anti-mutagenic and anticancer properties, antimicrobial activities, and potential anti-obesity characteristics and so on. So MPs have potential applications in different fields (Feng et al. 2012).
MPs biosynthesis is generally considered to follow a polyketide pathway similar to citrinin and MK, but their biosynthesis pathway is unclear and controversial for a long time (Turner 1971; Jůlová et al. 1994; Feng et al. 2012). Balakrishnan et al. (2013) firstly cloned a putative MPs biosynthetic gene cluster including 24 genes based on the DNA sequence amplified from an albino W13 with T-DNA insertions, and the expression level of mppR1(a transcription factor gene) and MpPKS5 (PKS gene) were significantly repressed in the albino. Targeted inactivation of MpPKS5 resulted in abolishment of pigment production, confirming MpPKS5 is involved in pigment biosynthesis. Similarly, a Chinese research group cloned a PKS gene with 8.1-kb length from a transformant with T-DNA insertion (Shao et al. 2009; Xie et al. 2013), and targeted-deletion of this PKS gene resulted in MPs depletion. Following this, a 53-kb flanking DNA sequences of the PKS was cloned by SON-PCR, and a putative gene cluster related to MPs synthesis was achieved, which consisted of a PKS gene, fatty acid synthases gene, esterase gene, dehydrogenase gene, transport protein, and regulator gene pigR (data not shown). The pigR-deleted strain absolutely lost the capacity to produce MPs (Xie et al. 2013). Whereafter, Liu et al. (2014) demonstrated ΔMpigE (encoding the putative aflatoxin aldehyde reductase) mutant just yielded four kinds of yellow MPs and very little red pigments, which is different from the parent strain with productivity of red, orange, and yellow pigments, suggesting that MpigE may be involved in the conversion among of different pigment compositions.
Related genes to G protein signal transduction pathway in Monascus spp.
The production of secondary metabolites is coupled with the general development of the fungus (Yu and Keller 2005). The link between these two different physiological processes is mediated through various signaling pathways, among of which, G protein signaling pathway has been intensively studied in various filamentous fungal species, especially in Aspergillus nidulans (Yu 2006). The heterotrimeric G protein composed of α, β, and γ subunits play pivotal roles in the G protein signaling pathway, and each subunit is very conserved (for extensive coverage on this topic, the reader is referred to these reviews: Yu and Keller 2005; Li et al. 2007; Servin et al. 2012).
In current years, the regulation of G protein heterotrimer consisting of α, β, and γ subunits (named Mga1, Mgb1and Mgg1, respectively), and MrflbA (the regulator of Mga1) to development and secondary metabolites production was investigated by site-specific recombination in M. ruber (Li et al. 2010a, 2014; Yang et al. 2012), and sequence analysis revealed the deduced amino acids of these genes described above shared significant similarity with those of Aspergillus spp. (Li et al. 2010a, 2014; Yang et al. 2012). FadA, α subunit of the heterotrimeric G protein, enhanced vegetative growth but repressed both sexual and asexual development and sterigmatocystin production in Aspergillus nidulans, as well as aflatoxin production in Aspergillus flavus and Aspergillus parasiticus (Yu and keller 2005). In M. ruber, Mga1 as well as Mgb1 and Mgg1 have been proven to promote both sexual and asexual development and vegetative growth but repress the production of citrinin and pigment (Li et al. 2010a, 2014). Absence of MrflbA resulted in overgrowth of vegetative growth followed by autolysis and an inhibition of pigment and citrinin production and sexual reproduction in M. ruber (Yang et al. 2012), but increased conidial number was observed, which was different from other regulators of α subunits of G protein, such as FlbA (Lee and Adams 1994), CAG8 (Fang et al. 2007), CPRGS-1 (Segers et al. 2004), BbRGS1 (Fang et al. 2008), and AfFlbA (Mah and Yu 2006).
Monascus genome
The genome of M. pilosus was first sequenced and assembled by the Bioresource Collection and Research Center of Taiwan in 2004, but it hasn’t been released until now. In 2010, the genome sequencing of M. ruber M7 was completed by de novo sequencing technique by Prof. Chen’s research group, and its genomic size is approximate 23.81 Mb including 8,407 predicted genes, in which a large number of potential genes (gene clusters) were predicted but poorly characterized (He et al. 2013). Whereafter, genomic DNAs of M. purpureus NRRL 1596 and M. ruber NRRL 1597 were also sequenced using the Illumina platform and assembled with Velvet and ALLPathsLG, and the assembled size of the genome was approximate 24 Mb (http://genome.jgi.doe.gov/). The data allow us to investigate the evolution of metabolic conservatism and diversity, and even unknown genes (gene clusters) responsible for secondary metabolites and regulation, as well as development and differentiation by genome mining approach (Kaplanl et al. 2011; Lackner et al. 2012; Blin et al. 2013; Royer et al. 2013).
Conclusion and outlook
The application of molecular tool for genetic manipulation has facilitated the understanding of Monascus spp., but we still know a little knowledge about the physiological and biochemical processes compared with other industrial fungi such as Penicillium chrysogenum, Aspergillus niger, and Aspergillus oryzae, and model fungi Aspergillus nidulans (Sun et al. 2007; Shimizu et al. 2009; de Bekker et al. 2011; Rank et al. 2012; Weber et al. 2012). Looking for the Monascus nucleotide sequence submitted to NCBI data (up to Oct 25 of 2013), there are no more than 0.5 % of gene sequences involved in development and metabolism (Table 4). Therefore, it is imperative to develop the manipulation system for high-throughput gene functional analysis of the genus of Monascus.
Route to improvement of gene recombination frequencies of Monascus spp.
It is well known that gene-targeted deletion by homologous recombination is a useful technique to study gene function in filamentous fungi. Normally, gene recombination frequencies (GRFs) of filamentous fungi are lower than 30 % (Weld et al. 2006; Meyer 2008; Kück and Hoff 2010) due to the competition with non-homologous end-joining (NHEJ). NHEJ is the dominant pathway in many eukaryotes, and its critically related genes include ku70, ku80, XRCC4, DNAPKcs, and LIG4 (Critchlow and Jackson 1998). Ku70 and Ku80 proteins by recruiting other NHEJ proteins play important roles in the NHEJ pathway, so deletion of Ku70 or (and) Ku80 can efficiently improve the GRFs of filamentous fungi (Ninomiya et al. 2004; da Silva Ferreira et al. 2006; Krappmann et al. 2006; Nayak et al. 2006; Pöggeler and Kück 2006; Meyer et al. 2007; Villalba et al. 2008; Chang et al. 2010; Li et al. 2010b). There is no exception that deletion of ku70 and ku80 genes can significantly improve GRFs of M. ruber (He et al. 2013).
Selective markers for multiple-gene functional analysis of Monascus spp.
During the process of gene deletion, effective selection marker is very important for rapid screening transformants. Antibiotic resistance genes and auxotrophic complementation are widely used as selection markers in genetic modification of filamentous fungi (Kopke et al. 2010). Hygromycin B (Chen et al. 2008a; Shao et al. 2009), phleomycin (Campoy et al. 2003), and aureobasidin A (Shimizu et al. 2006) have been successfully applied to the transformation of Monascus spp.. However, antibiotic resistance markers should be avoided for food applications from the point view of safety. So Wang et al. (2010) screened a PyrG mutant (the uridine auxotrophic strain, named UM28) from M. aurantiacus AS3.4384 as well as cloned the pyrG gene (encoding orotidine-5′-phosphate decarboxylase), and plasmid with pyrG gene could be transformed into PyrG mutant by using pyrG as a selection marker, which is available to transform Monascus spp. as a food-grade selection marker. In any case, the numbers of available antibiotic markers are limited, and creating auxotrophic mutants is a time-consuming process, making it difficult to delete multiple sequential genes in a single strain.
In recent years, recycled marker techniques dependent on recombinase system have been developed to replace selection markers in both prokaryotes and eukaryotes, which have broken through the limitation of selection markers in the genetic manipulation (Krappmann et al. 2005). The classical feature to this system is the ability to recombine substrate with two different or identical short DNA sequences as recognition sites. The best-exemplified members of the integrase family are the λ-integrase of bacteriophage λ (Van Duyne 2001), the recombinase Cre of Escherichia coli bacteriophage P1 (Abremski and Hoess 1984) and the XerCD proteins of E. coli (Blakely et al. 2000) and the eukaryotic FLP recombinase of Saccharomyces cerevisiae (Chen and Rice 2003). Up to now, FLP/FRT recombination system has been successfully applied to bacteria as well as to several eukaryotes. Kopke et al. (2010) demonstrated the recycling applicability of FLP/FRT recombination system to excise the resistance marker in P. chrysogenum and Sordaria macrospora, suggesting its applicable prospect in other filamentous fungi.
Direction to citrinin, MK, and MPs and their regulation
Although the gene clusters involving in the synthesis of citrinin, MK and MPs are isolated and analyzed by bioinformatics tools, and the effect of several genes on their production has been assessed, following questions still need to be further elucidated: (1) How many genes are directly responsible for the biosynthesis of citrinin, MKs, and MPs? (2) How does the single gene in each cluster play the role in the biosynthetic pathway? (3) What is the relationship among the metabolic pathway such as MPs, citrinin and MK? And (4) how do three kinds of MPs compounds convert? Hence, much effort must be paid to study the biosynthesis pathway described above.
It is well known that secondary metabolite production is regulated by many other mechanisms, for instance, Lae A—a global transcriptional regulator, was proved to positively regulate secondary metabolites production in several filamentous fungi (Bok and Keller 2004; Kosalkova et al. 2009). Lee et al. (2013) also attempted to overexpress an ortholog of the laeA gene drived by the alcA promoter of Aspergillus nidulans in M. pilosus, and the results revealed that MK, pigment, and the antioxidant activity of Monascus-fermented product from overexpressed strains were significantly increased than those of wild strain, suggesting that Monascus species can be improved for the production of bioactive substances by overexpressing the laeA gene.
In addition to the described regulation pathway, several other regulation mechanisms, such as transcription factor, histone deacetylase, DNA methyltransferase, hormone-like signaling molecules, signaling proteins such as MAP kinases and cAMP-dependent protein kinases (Fox and Howlett 2008) also participate in this process, which have laid foundation for further investigation of their functions in M. ruber.
References
Abremski K, Hoess R (1984) Bacteriophage P1 site-specific recombination. Purification and properties of the Cre recombinase protein. J Biol Chem 259:1509–1514
Aniya Y, Ohtani II, Higa T, Miyagi C, Gibo H, Shimabukuro M, Nakanish H, Taira J (1999) Dimerumic acid as an antioxidant of the mold, Monascus anka. Free Radic Biol Med 286:999–1004
Arunachalam C, Narmadhapriya D (2011) Monascus fermented rice and its beneficial aspects: a new review. Asian J Pharm Clin Res 4:29–31
Balakrishnan B, Karki S, Chiu SH, Kim HJ, Suh JW, Nam B, Yoon YM, Chen CC, Kwon HJ (2013) Genetic localization and in vivo characterization of a Monascus azaphilone pigment biosynthetic gene cluster. Appl Microbiol Biotechnol 97:6337–6345
Barnard EL, Cannon PF (1987) A new species of Monascus from pine tissues in Florida. Mycologia 79:479–484
Blakely GW, Davidson AO, Sherratt DJ (2000) Sequential strand exchange by XerC and XerD during site-specific recombination at dif. J Biol Chem 275:9930–9936
Blanc PJ, Laussac JP, Le Bars J, Le Bars P, Loret MO, Pareilleux A, Prome D, Prome JC, Santerre AL, Goma G (1995a) Characterization of monascidin A from Monascus as citrinin. Int J Food Microbiol 27:201–213
Blanc PJ, Loret MO, Goma G (1995b) Production of citrinin by various species of Monascus. Biotechnol Lett 17:291–294
Blin K, Medema MH, Kazempour D, Fischbach MA, Breitling R, Takano E, Weber T (2013) antiSMASH 2.0—a versatile platform for genome mining of secondary metabolite producers. Nucleic Acids Res 1–9
Bok JW, Keller NP (2004) LaeA, a regulator of secondary metabolism in Aspergillus spp. Eukaryot Cell 3:527–535
Brakhage AA (2013) Regulation of fungal secondary metabolism. Nat Rev Microbiol 11:21–32
Brakhagea AA, Schroeckha V (2011) Fungal secondary metabolites—strategies to activate silent gene clusters. Fungal Genet Biol 48:15–22
Cai QM, Jiang DH, Ji H, Lan LJ (2010) Establishment and optimization of Agrobacterium-mediated transformation systems for Monascus purpureus. J Microbiol 30:68–73, Chinese
Campoy S, Pérez F, Martin JF, Gutiérrez S, Liras P (2003) Stable transformants of the azaphilone pigment-producing Monascus purpureus obtained by protoplast transformation and Agrobacterium-mediated DNA transfer. Curr Genet 43:447–452
Cannon PF, Abdullah SK, Abbas BA (1995) Two new species of Monascus from Iraq, with a key to known species of the genus. Mycol Res 99:659–662
Case ME, Schweizer M, Kunshner SR, Giles N (1979) Efficient transformation of Neurospora crassa by utilizing hybrid plasmid DNA. Proc Natl Acad Sci U S A 76:5259–5263
Chang PK, Scharfenstein LL, Wei Q, Bhatnagar D (2010) Development and refinement of a high-efficiency gene-targeting system for Aspergillus flavus. J Microbiol Meth 81:240–246
Chen FS, Hu XQ (2005) Study on red fermented rice with high concentration of monacolin K and low concentration of citrinin. Int J Food Microbiol 103:331–337
Chen Y, Rice PA (2003) New insight into site-specific recombination from Flp recombinase-DNA structures. Annu Rev Biophys Biomol Struct 32:135–159
Chen YP, Tseng CP, Liaw LL, Wang CL, Yuan GF (2007) Characterization of MRT, a new non-LTR retrotransposon in Monascus spp. Bot Stud 48:377–385
Chen YP, Chen IQ, Hwang IE, Yuan GF, Ling LL, Tseng CP (2008a) Selection of an effective red-pigment producing Monascus pilosus by efficient transformation with aurintricarboxylic acid. Biosci Biotechnol Biochem 72:3021–3024
Chen YP, Tseng CP, Liaw LL, Wang CL, Chen IC, Wu WJ, Wu MD, Yuan GF (2008b) Cloning and characterization of monacolin K biosynthetic gene cluster from Monascus pilosus. J Agric Food Chem 56:5639–5646
Chen YP, Yuan GF, Hsieh SY, Lin YS, Wang WY, Liaw LL, Tseng CP (2010) Identification of the mokH gene encoding transcription factor for the.upregulation of monacolin K biosynthesis in Monascus pilosus. J Agric Food Chem 58:287–293
Critchlow SE, Jackson SP (1998) DNA end-joining: from yeast to man. Trends Biochem Sci 23:394–398
da Silva Ferreira ME, Kress MRVZ, Savoldi M, Goldman MHS, Härtl A, Heinekamp T, Brakhage AA, Goldman GH (2006) The akuBKU80 mutant deficient for nonhomologous end joining is a powerful tool for analyzing pathogenicity in Aspergillus fumigatus. Eukaryot Cell 5:207–211
de Bekker C, Bruning O, Jonker MJ, Breit TM, Wösten HAB (2011) Single cell transcriptomics of neighboring hyphae of Aspergillus niger. Genome Biol 12:R71
Endo A (1979) Monacolin K, a new hypocholesterolemic agent produced by a Monascus species. J Antibiot 32:852–854
Endo A, Hasumi K, Negishi S (1985) Monacolin J and L, new inhibitors of cholesterol biosynthesis produced by Monascus ruber. J Antibiot 38:420–422
Endo A, Komagata D, Shimada H (1986) Monacolin M: a new inhibitor of cholesterol biosynthesis. J Antibiot 39:1670–1673
Fang WG, Pei Y, Bidochka MJ (2007) A regulator of a G protein signaling (RGS) gene, cag8, from the fungus Metarhizium anisopliae is involved in conidiation, virulence and hydrophobin synthesis. Microbiology 153:1017–1025
Fang WG, Scully LR, Zhang L, Pei Y, Bidochka MJ (2008) Implication of a regulator of G protein signalling (BbRGS1) in conidiation and conidial thermotolerance of the insect pathogenic fungus Beauveria bassiana. FEMS Microbiol Lett 279:146–156
Feng YL, Shao YC, Chen FS (2012) Monascus pigment. Appl Microbiol Biotechnol 96:1421–1440
Fox EM, Howlett BJ (2008) Secondary metabolism: regulation and role in fungal biology. Curr Opin Microbiol 11:481–487
Fu GM, Xu Y, Li YP, Tan WH (2007) Construetion of a replacement vector to disrupt pksCT gene for the mycotoxin citrinin biosynthesis in Monascus aurantiacus and maintain food red pigment production. Asia Pac J Clin Nutr 16(Suppl 1):137–142
Geiser DM, Gueidan C, Miadlikowska J, Lutzoni F, Kauff F, Hofstetter V, Fraker E, Schoch CL, Tibell L, Untereiner WA, Aptroot A (2006) Eurotiomycetes: eurotiomycetidae and Chaetothyriomycetidae. Mycologia 98:1053–1064
Grabley S, Thiericke R (1999) Drug discovery from nature. Springer, Berlin
Hajjaj H, Francois JM, Goma G, Blanc PJ (2012) Effect of amino acids on red pigments and citrinin production in Monascus ruber. J Food Sci 77:156–159
Hawksworth DL, Pitt JI (1983) A new taxonomy for Monascus species based on cultural and microscopical characters. Aust J Bot 31:51–61
He Y, Liu QP, Shao YC, Chen FS (2013) ku70 and ku80 null mutants improve the gene targeting frequency in Monascus ruber M7. Appl Microbiol Biotechnol 97:4965–4976
Hocking AD, Pitt JI (1988) Two new species of xerophilic fungi and a further record of Eurotium halophilicum. Mycologia 80:82–88
Hsu WH, Pan TM (2012) Monascus purpureus-fermented products and oral cancer: a review. Appl Microbiol Biotechnol 93:1831–1842
Hsu WH, Liao TH, Lee BH, Hsu YW, Pan TM (2013) Ankaflavin regulates adipocyte function and attenuates hyperglycemia caused by high-fat diet via PPAR-c activation. J Funct Foods 5:124–132
Hutchinson CR, Kennedy J, Park C, Kendrew S, Auclair K, Vederas J (2000) Aspects of the biosynthesis of non-aromatic fungal polyketides by iterative polyketide synthases. Antonie Van Leeuwenhoek 78:287–295
Jia XQ, Xu ZN, Zhou LP, Sung CK (2010) Elimination of the mycotoxin citrinin production in the industrial important strain Monascus purpureus SM001. Metab Eng 12:1–7
Jůlová P, Martínkková L, Lozinski J, Machek F (1994) Ethanol as substrate for pigment production by the fungus Monascus purpureus. Enzym Microb Technol 16:996–1001
Kaplanl O, Bezouška K, Malandra A, VeseláAB PA, Felsberg J, Rinágelová A, Křen V, Martínková L (2011) Genome mining for the discovery of new nitrilases in filamentous fungi. Biotechnol Lett 33:309–312
Kennedy J, Auclair K, Kendrew SG, Park C, Vederas JC, Hutchinson CR (1992) Modulation of polyketide synthase activity by accessory proteins during lovastatin biosynthesis. Science 284:1368–1372
Kim JG, Choi YD, Chang YJ, Kim SU (2003) Genetic transformation of Monascus purpureus DSM1379. Biotechnol Lett 25:1509–1514
Kopke K, Hoff B, Kück U (2010) Application of the Saccharomyces cerevisiae FLP/FRT recombination system in filamentous fungi for marker recycling and construction of knockout strains devoid of heterologous genes. Appl Environ Microbial 76:4664–4674
Kosalkova K, Garcia-Estrada C, Ullan RV, Godio RP, Feltrer R, Teijeira F, Mauriz E, Martin JF (2009) The global regulator LaeA controls penicillin biosynthesis, pigmentation and sporulation, but not roquefortine C synthesis in Penicillium chrysogenum. Biochimie 91:214–225
Krappmann S, Bayram O, Braus GH (2005) Deletion and allelic exchange of the Aspergillus fumigatus veA locus via a novel recyclable marker module. Eukaryot Cell 4:1298–1307
Krappmann S, Sasse C, Braus GH (2006) Gene targeting in Aspergillus fumigatus by homologous recombination is facilitated in a nonhomologous end-joining-deficient genetic background. Eukaryot Cell 5:212–215
Kück U, Hoff B (2010) New tools for the genetic manipulation of filamentous fungi. Appl Microbiol Biotechnol 86:51–62
Lackner G, Misiek M, Braesel J, Hoffmeister D (2012) Genome mining reveals the evolutionary origin and biosynthetic potential of basidiomycete polyketide synthases. Fungal Genet Biol 49:996–1003
Lakrod K, Chaisrisook C, Yongsmith B, Skinner DZ (2000) RAPD analysis of genetic variation within a collection of Monascus spp. isolated from red rice (ang-kak) and sofu. Mycol Res 104:403–408
Lakrod K, Chaisrisook C, Skinner DZ (2003a) Expression of pigmentation genes following electroporation of albino Monascus purpureus. J Ind Microbiol Biotechnol 30:369–374
Lakrod K, Chaisrisook C, Daniel ZS (2003b) Transformation of Monascus purpureus to hyromycing B resistance with cosmid pMOcosX reduces fertility. Electron J Biotechnol 6:143–147
Lee BN, Adams HT (1994) Overexpression of flbA, an early regulator of Aspergillus asexual sporulation, leads to activation of brlA and premature initiation of development. Mol Microbiol 14:323–334
Lee CL, Pan TM (2011) Red mold fermented products and Alzheimer’s disease: a review. Appl Microbiol Biotechnol 91:461–469
Lee BH, Pan TM (2012) Benefit of Monascus-fermented products for hypertension prevention: a review. Appl Microbiol Biotechnol 94:1151–1161
Lee BH, Pan TM (2013) Dimerumic acid, a novel antioxidant identified from Monascus-fermented products exerts chemoprotective effects: mini review. J Funct Foods 5:2–9
Lee CL, Hung HK, Wang JJ, Pan TM (2007) Improving the ratio of monacolin K to citrinin production of Monascus purpureus NTU 568 under dioscorea medium through the mediation of pH value and ethanol addition. J Agric Food Chem 55:6493–6502
Lee SS, Lee JH, Lee I (2013) Strain improvement by overexpression of the laeA gene in Monascus pilosus for the production of Monascus-fermented rice. J Microbiol Biotechnol 23:959–965
Li ZQ (1982) A new species of the genus Monascus aurantiacus. Acta Microbiol Sin 22:118–122, Chinese
Li ZQ, Guo F (2003) Morphology and taxonomy of Monascus. Chinese Light Industry Press, Beijing
Li LD, Wright SJ, Krystofova S, Park G, Borkovich KA (2007) Heterotrimeric G protein signaling in filamentous fungi. Annu Rev Microbiol 61:423–452
Li L, Shao YC, Li Q, Yang S, Chen FS (2010a) Identification of Mga1, a G-protein α-subunit gene involved in regulating citrinin and pigment production in Monascus ruber M7. FEMS Microbiol Lett 308:108–114
Li ZH, Du CM, Zhong YH, Wang TH (2010b) Development of a highly efficient gene targeting system allowing rapid genetic manipulations in Penicillium decumbens. Appl Microbiol Biotechnol 87:1065–1076
Li YP, Xu Y, Huang ZB (2012) Isolation and characterization of the citrinin biosynthetic gene cluster from Monascus aurantiacus. Biotechnol Lett 34:131–136
Li YP, Pan YF, Zou LH, Xu Y, Huang ZB, He QH (2013) Lower citrinin production by gene disruption of ctnB involved in citrinin biosynthesis in Monascus aurantiacus Li AS3.4384. J Agric Food Chem 61:7397–7402
Li L, He L, Lai Y, Shao YC, Chen FS (2014) Cloning and functional analysis of the Gβ gene Mgb1 and the Gγ gene Mgg1 in Monascus ruber. J Microbiol 52:35–43
Lin YL, Wang TH, Lee MH, Su NW (2008) Biologically active components and nutraceuticals in the Monascus- fermented rice: a review. Appl Microbiol Biotechnol 77:965–973
Liu MT, Wang AL, Sun Z, Li JJ, Wu XL, Liu YX, Shang XY (2003) Cytotoxic monacolin analogs from Monascus purpureus-fermented rice. J Asian Nat Prod Res 15:600–609
Liu QP, Xie NN, He Y, Wang L, Shao YC, Zhao HZ, Chen FS (2014) MpigE, a gene involved in pigment biosynthesis in Monascus ruber M7. Appl Microbiol Biotechnol 98:285–296
Mah JH, Yu JH (2006) Upstream and downstream regulation of asexual development in Aspergillus fumigates. Eukaryotic Cell 10:1585–1595
Malmstrøm J, Christophersen C, Frisvad JC (2000) Secondary metabolites characteristic of Penicillium citrinum, Penicillium steckii and related species. Phytochemistry 54:301–309
Meyer V (2008) Genetic engineering of filamentous fungi-progress, obstacles and future trends. Biotechnol Adv 26:177–185
Meyer V, Arentshorst M, El-Ghezal A, Drews AC, Kooistra R, van den Hondel CAMJJ, Ram AFJ (2007) Highly efficient gene targeting in the Aspergillus niger kusA mutant. J Biotechnol 128:770–775
Michielse CB, Hooykaas PJJ, van den Hondel CA, Ram AFJ (2005) Agrobacterium-mediated transformation as a tool for functional genomics in fungi. Curr Genet 48:1–17
Nayak T, Szewczyk E, Oakley CE, Osmani A, Ukil L, Murray SL, Hynes MJ, Osmani SA, Oakley BR (2006) A versatile and efficient gene-targeting system for Aspergillus nidulans. Genetics 172:1557–1566
Ninomiya Y, Suzuki K, Ishii C, Inoue H (2004) Highly efficient gene replacements in Neurospora strains deficient for nonhomologous end-joining. Proc Natl Acad Sci U S A 101:12248–12253
Park HG, Jong SC (2003) Molecular characterization of Monascus strains based on the D1/D2 regions of LSU rRNA genes. Mycoscience 44:25–32
Park HG, Elena KS, Jong SC (2004) Phylogenetic relationships of Monascus species inferred from the ITS and the partial β-tubulin gene. Bot Bull Acad Sin 45:325–330
Patakova P (2013) A review: Monascus secondary metabolites: production and biological activity. J Ind Microbiol Biotechnol 40:169–181
Pattanagul P, Pinthong R, Phianmongkhol A, Tharatha S (2008) Mevinolin, citrinin and pigments of adlay angkak fermented by Monascus sp. Int J Food Microbiol 126:20–23
Pöggeler S, Kück U (2006) Highly efficient generation of signal transduction knockout mutants using fungal strain deficient in the mammalian ku70 ortholog. Gene 378:1–10
Rank C, Klejnstrup ML, Petersen LM, Kildgaard S, Frisvad JC, Gotfredsen CH, Larsen TO (2012) Comparative chemistry of Aspergillus oryzae (RIB40) and A .flavus (NRRL 3357). Metabolites 2:39–56
Royer M, Koebnik R, Marguerettaz M, Barbe V, Robin GP, Brin C, Carrere S, Gomez C, Hügelland M, Völler GH, Noëll J, Pierett I, Rausch S, Verdier V, Poussier S, Rott P, Süssmuth RD, Cociancich S (2013) Genome mining reveals the genus Xanthomonas to be a promising reservoir for new bioactive non-ribosomally synthesized peptides. BMC Genomics 14:1–19
Sakai K, Kinoshita H, Shimizu T, Nihira T (2008) Construction of a citrinin gene cluster expression system in heterologous Aspergillus oryzae. J Biosci Bioeng 106:466–472
Sakai K, Kinoshita H, Nihira T (2009) Identification of mokB involved in monacolin K biosynthesis in Monascus pilosus. Biotechnol Lett 31:1911–1916
Segers GC, Regier JC, Nuss DL (2004) Evidence for a role of the regulator of G-protein signaling protein CPRGS-1 in Ga subunit CPG-1-mediated regulation of fungal virulence, conidiation, and hydrophobin synthesis in the chestnut blight ungus Cryphonectria parasitica. Eukaryotic Cell 3:1454–1463
Servin JA, Campbell AJ, Borkovich KA (2012) G-protein signaling components in filamentous fungal genomes. In: Witzany G (ed) Biocommunication of Fungi. Springer, Berlin, pp 21–38
Shao YC, Wang RY, Ding YD, Chen FS, Xie BJ (2006) Construction of T-DNA insertional library of Monascus mediated by Agrobacterium tumefaciens and characteristic analysis of the color mutants. Mycosystema 25:247–255, Chinese
Shao YC, Ding YD, Zhao Y, Yang S, Xie BJ, Chen FS (2009) Characteristic analysis of transformants in T-DNA mutation library of Monascus ruber. World J Microbiol Biotechnol 25:989–995
Shao YC, Xu L, Chen FS (2011) Genetic diversity analysis of Monascus strains using SRAP and ISSR markers. Mycoscience 52:224–233
Shi YC, Pan TM (2011) Beneficial effects of Monascus purpureus NTU 568-fermented products: a review. Appl Microbiol Biotechnol 90:1207–1217
Shi YC, Pan TM (2012) Red mold, diabetes, and oxidative stress: a review. Appl Microbiol Biotechnol 94:47–55
Shimizu T, Kinoshita H, Ishihara S, Sakai K, Nagai S, Nihira T (2005) Polyketide synthase gene responsible for citrinin biosynthesis in Monascus purpureus. Appl Environ Microbiol 71:3453–3457
Shimizu T, Kinoshita H, Nihira T (2006) Development of transformation system in Monascus purpureus using an autonomous replication vector with aureobasidin A resistance gene. Biotechnol Lett 28:115–120
Shimizu T, Kinoshita H, Nihira T (2007) Identification and in vivo functional analysis by gene disruption of ctnA, an activator gene involved in citrinin biosynthesis in Monascus purpureus. Appl Environ Microbiol 73:5097–5103
Shimizu M, Fujii T, Masuo S, Fujita K, Takaya N (2009) Proteomic analysis of Aspergillus nidulans cultured under hypoxic conditions. Proteomics 9:7–19
Shinzato N, Namihira T, Tamaki Y, Tsukahara M, Matsui T (2009) Application of random amplified polymorphic DNA (RAPD) analysis coupled with microchip electrophoresis for high-resolution identification of Monascus strains. Appl Microbiol Biotechnol 82:1187–1193
Sorensen JL, Auclair K, Kennedy J, Hutchinson CR, Vederas JC (2003a) Transformations of cyclic nonaketides by Aspergillus terreus mutants blocked for lovastatin biosynthesis at the lov A and lov C genes. Org Biomol Chem 1:50–59
Sorensen JL, Vederas JC, Monacolin N (2003b) A compound resulting from derailment of type I iterative polyketide synthase functionen route to lovastatin. Chem Commun 13:1492–1493
Staunton J, Weissman KJ (2001) Polyketide biosynthesis: a millennium review. Nat Prod Rep 18:380–416
Stchigel AM, Cano J, Abdullah SK, Guarro J (2004) New and interesting species of Monascus from soil, with a key to the known species. Stud Mycol 50:299–306
Su YC, Wang JJ, Lin TT, Pan TM (2003) Production of the secondary metabolites γ-aminobutyric acid and monacolin K by Monascus. J Ind Microbiol Biotechnol 30:40–46
Sun JB, Lu X, Rinas U, Zeng AP (2007) Metabolic peculiarities of Aspergillus niger disclosed by comparative metabolic genomics. Genome Biol 8:R182
Sweeney MJ, Dobson A (1998) Mycotoxin production by Aspergillus, Fusarium and Penicillium species. Int J Food Microbiol 43:141–158
Turner WB (1971) Fungal metabolites. Academic, London
Udagawa SI, Baba H (1998) Monascus lunisporas: a new species isolated from moldy feeds. Cryptogam Mycol 19:269–276
Van Duyne GD (2001) A structural view of cre-loxp site-specific recombination. Annu Rev Biophys Biomol Struct 30:87–104
Villalba F, Collemare J, Landraud P, Lambou K, Brozek V, Cirer B, Morin D, Bruel C, Beffa R, Lebrun MH (2008) Improved gene targeting in Magnaporthe grisea by inactivation of MgKU80 required for non-homologous end joining. Fungal Genet Biol 45:68–75
Wang YZ, Ju XL, Zhou YG (2005) The variability of citrinin production in Monascus type cultures. Food Microbiol 22:145–148
Wang BH, Xu Y, Li YP (2010) Use of the pyrG gene as a food-grade selection marker in Monascus. Biotechnol Lett 32:1631–1635
Wang L, Wang W, Xu GR (2011) Promotion of monacolin K production by Agrobacterium tumefaciens—mediated transformation in Monascus albidus 9901. Curr Microbiol 62:501–507
Weber SS, Bovenberg RAL, Driessen AJM (2012) Biosynthetic concepts for the production of β-lactam antibiotics in Penicillium chrysogenum. Biotechnol J 7:225–236
Weld RJ, Plummer KM, Carpenter MA, Ridgway HJ (2006) Approaches to functional genomics in filamentous fungi. Cell Res 16:31–44
Wiemann P, Guo CJ, Palmer JM, Sekonyela R, Wang CC, Keller NP (2013) Prototype of an intertwined secondary metabolite supercluster. Proc Natl Acad Sci U S A 110:17065–17070
Wong HC, Koehler P (1981) Production and isolation of an antibiotic from Monascus purpureus and its relationship to pigment production. J Food Sci 46:589–592
Xie NN, Liu QP, Chen FS (2013) Deletion of pigR gene in Monascus ruber leads to loss of pigment production. Biotechnol Lett 35:1425–1432
Yang YJ, Lee IH (2008) Agrobactrium tumefaciens-mediated transformation of Monascus ruber. J Microbiol Biotechnol 18:754–758
Yang YS, Li L, Li X, Shao YC, Chen FS (2012) mrflbA, encoding a putative FlbA, is involved in aerial hyphal development and secondary metabolite production in Monascus ruber M7. Fungal Biol 116:225–233
Yu JH (2006) Heterotrimeric G protein signaling and RGSs in Aspergillus nidulan. J Microbiol 44:145–154
Yu JH, Keller NP (2005) Regulation of secondary metabolism in filamentous fungi. Annu Rev Phytopathol 43:437–458
Zhang MY, Miyake T (2007) Identification of a cerulenin resistance gene from Monascus pilosus. DNA Seq 18:68–72
Zhang MY, Miyake T (2009) Development and media regulate alternative splicing of a methyltransferase Pre-mRNA in Monascus pilosus. J Agric Food Chem 57:4162–4167
Zhang T, Qi Z, Wang YY, Zhang FY, Li RY, Yu QS, Chen XB, Wang HJ, Xiong X, Tang KX (2013) Agrobacterium tumefaciens-mediated transformation of Penicillium expansum PE-12 and its application in molecular breeding. Microbiol Res 168:130–137
Zhou LH,Wang ZX, Zhu-Ge J (2006) Comparison of different transformation methods for Monascus sp. Hereditas 479– 485, Chinese
Zhou YX, Chen JB, Dong LN, Chen FS, Hu DJ, Wang XH (2012) A study of fluorescence properties of citrinin in beta-cyclodextrin aqueous solution and different solvents. J Lumin 132:1437–1445
Acknowledgments
The authors acknowledge the members of Food Biotechnology and Food Safety Laboratory in Huazhong Agricultural University in Wuhan of China for their dedicated work. Research in Monascus spp. is supported by Major Program of National Natural Science Foundation of China (no. 31330059) and National Natural Science Foundation of China (nos. 31271834, 31171649, and 31371824).
Author information
Authors and Affiliations
Corresponding author
Rights and permissions
About this article
Cite this article
Shao, Y., Lei, M., Mao, Z. et al. Insights into Monascus biology at the genetic level. Appl Microbiol Biotechnol 98, 3911–3922 (2014). https://doi.org/10.1007/s00253-014-5608-8
Received:
Revised:
Accepted:
Published:
Issue Date:
DOI: https://doi.org/10.1007/s00253-014-5608-8